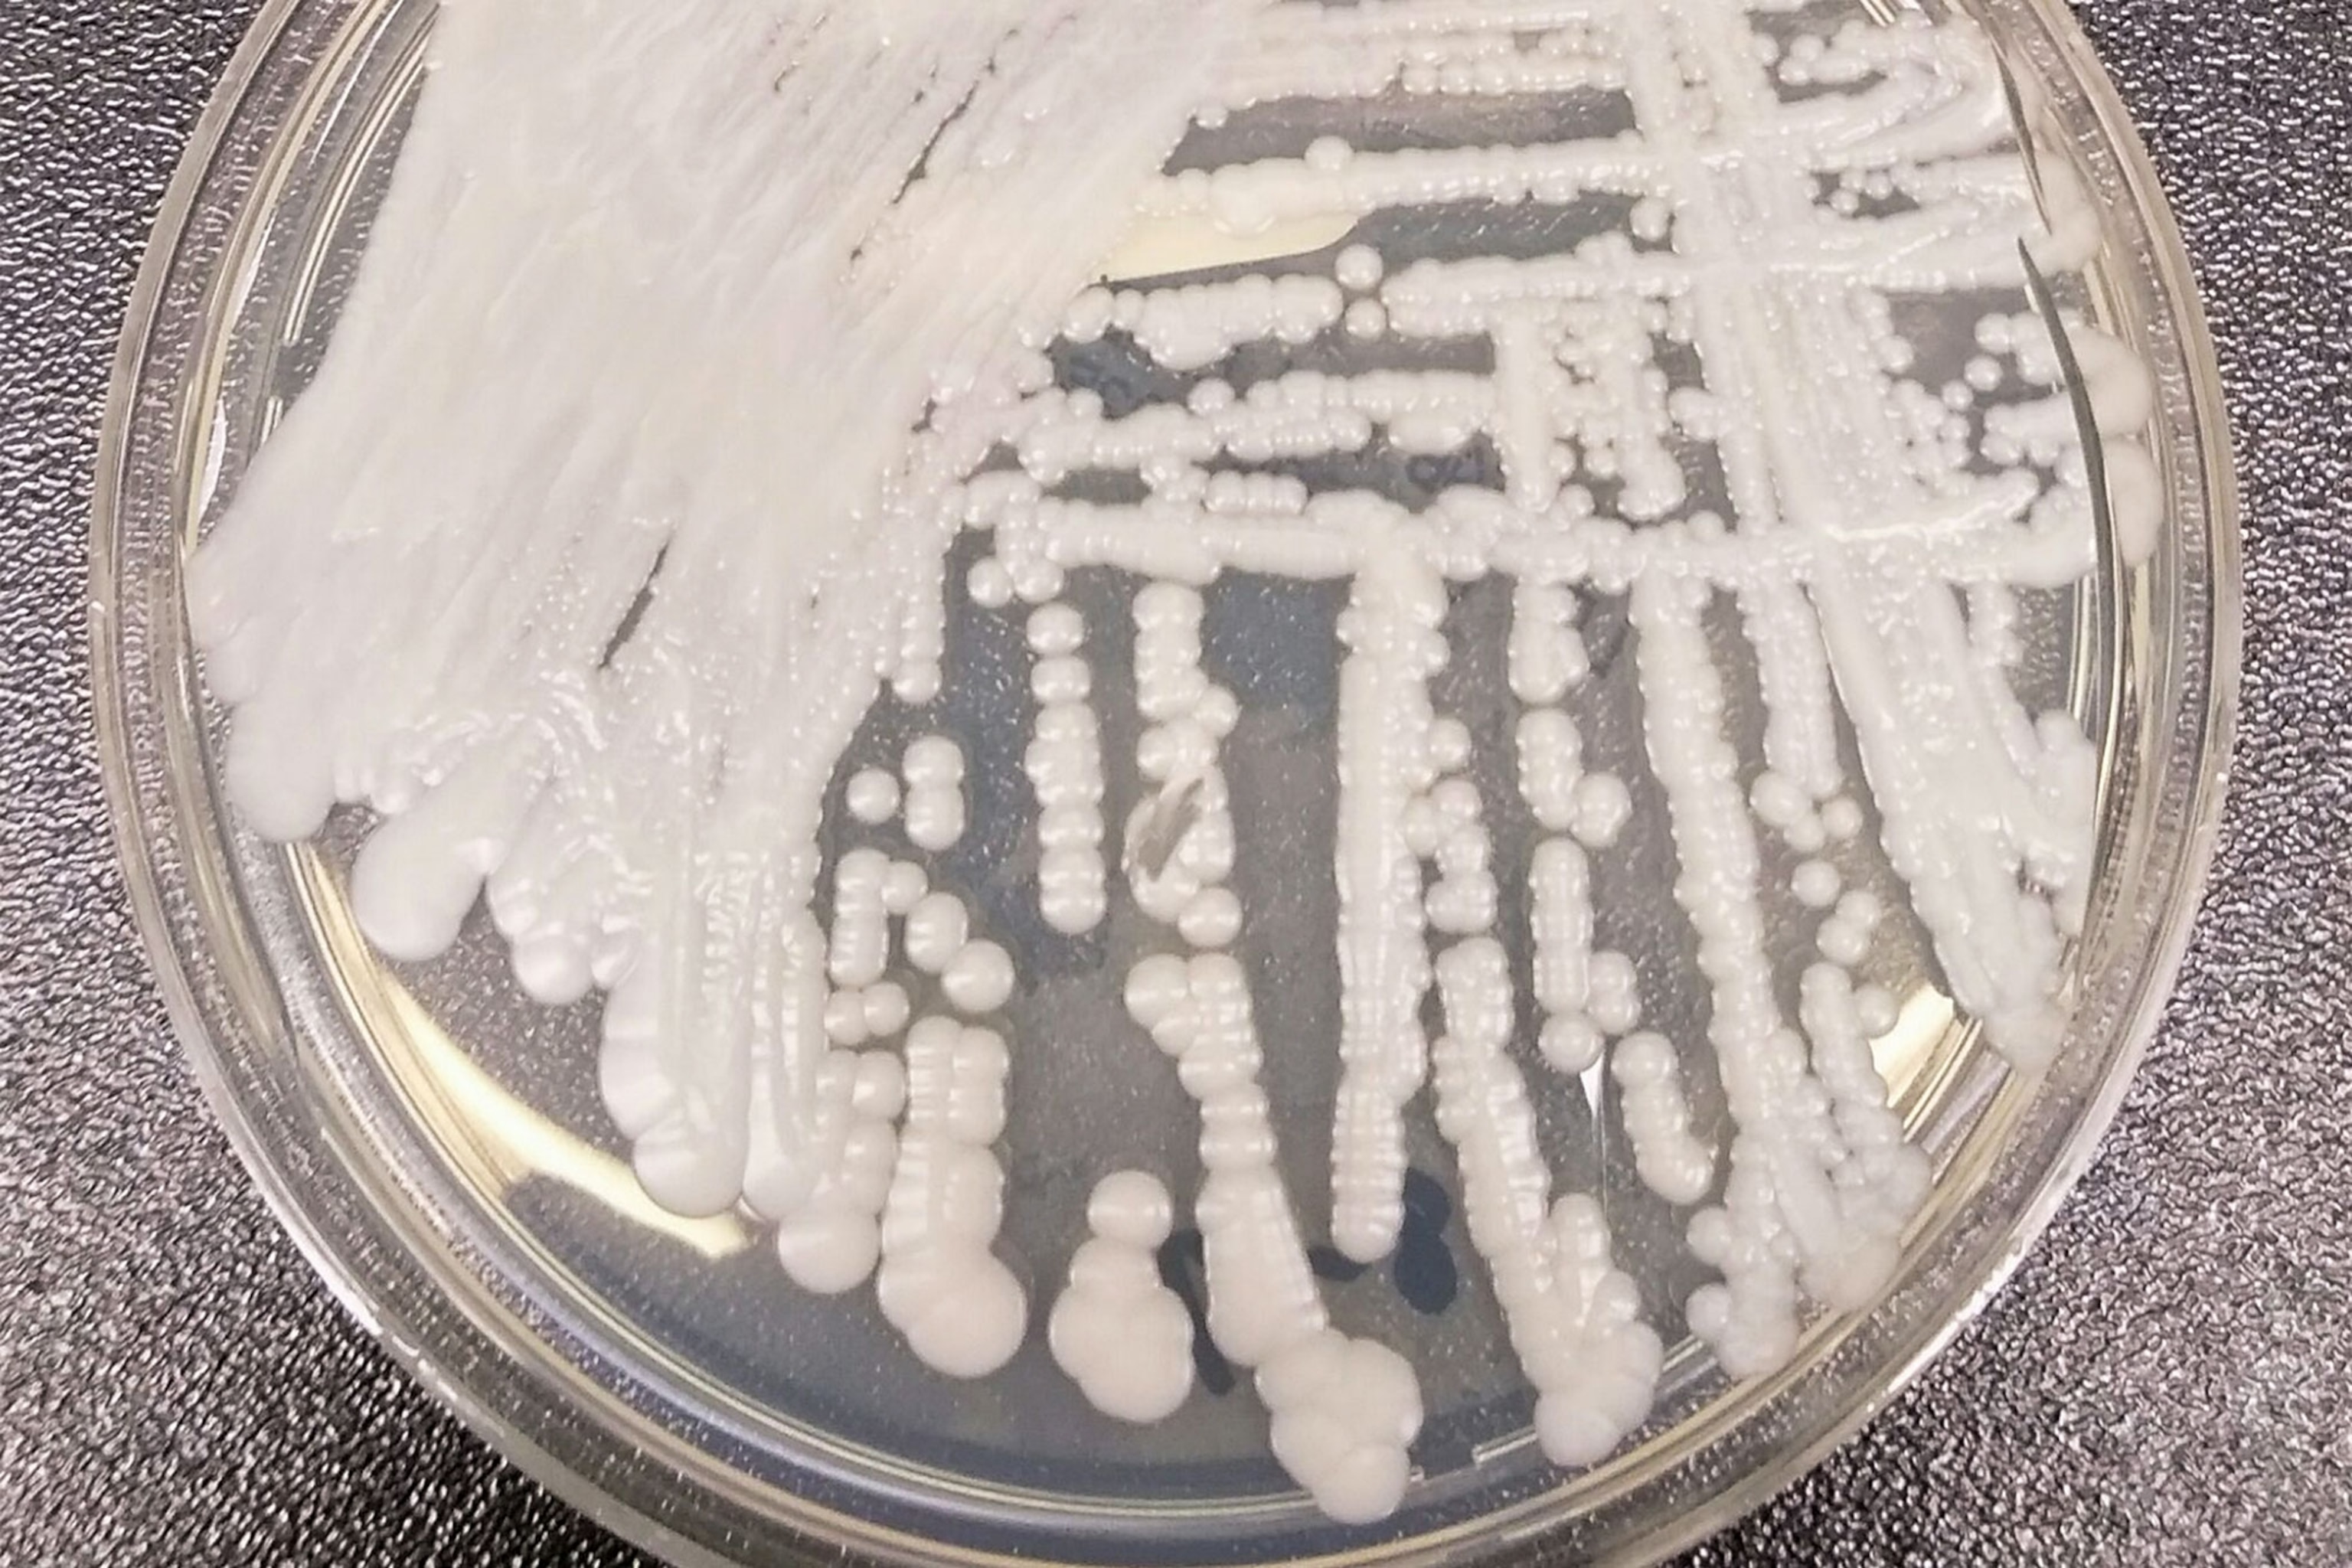
yeast in a petri dish

Fatal Fungus Linked to 4 New Deaths—What You Need to Know
Get the facts about a lethal yeast that isn’t responding to known drugs and is causing hospital outbreaks around the globe.
Thirteen people in the United States have been sickened by a deadly form of drug-resistant yeast that has spread across the world since 2009, and four of those people have died, the Centers for Disease Control and Prevention said on November 4.
The new yeast superbug, called Candida auris, causes outbreaks in a way that has never been seen before, and it doesn’t respond to the few drugs available to treat fungal infections. CDC scientists are urgently studying it to understand how it spreads and how it can be controlled.
“I am worried,” says Tom Chiller, a physician who is chief of the CDC’s mycotic diseases branch. “I think this is a real threat.”
What does this yeast do to people?
C. auris is causing very serious wound and bloodstream infections in people who are already hospitalized and ill. So it’s behaving like the bacteria that are known to cause deadly health-care–associated infections—organisms such as MRSA, Klebsiella, and Acinetobacter that reach patients on health-care workers’ hands and via contaminated hospital equipment. Like these bacteria, it causes overwhelming infections that swamp the immune system and don’t respond to drugs. Just one problem: Fungi, and especially yeasts, have never behaved this way before.
How long has this been around?
Starting in 2009, when one patient in Japan got sick, physicians on different continents began telling each other that they were seeing hospital outbreaks of a fungus that had never been recorded before and that didn't respond to antifungal drugs. By earlier this year, drug-resistant C. auris had been reported in South Korea, India, Kuwait, South Africa, and several countries in South America. In October, doctors in London announced in a medical journal that an outbreak in their hospital sickened 50 patients and lasted for more than a year. In various locations, up to two-thirds of those who've been infected with this new fungus have died.
Is this yeast new in the United States?
The CDC announcement marks the second time this year the agency has raised the alarm about C. auris. In June, the CDC sent a warning to U.S. hospitals to begin watching for the pathogen, alerting them that C. auris behaves in ways that are unlike other fungal infections and that it's both difficult to detect and hard to treat. (See “New and Deadly Drug-Resistant Yeast Emerges Globally.”)
Now, in a special edition of its weekly bulletin, the CDC says that the warning elicited reports of seven sick patients in New York, New Jersey, Maryland, and Illinois. Of those infected, four people have died. Chiller adds that since the agency began writing the bulletin, six additional cases have been reported. None of the cases are related, and none of the patients have anything in their recent past that would explain their infections. But four of them—the two in Illinois and one each from New Jersey and Maryland—were housed in the same health-care institutions at different times.
Is this disease like a yeast infection?
This isn’t the kind of yeast that causes vaginal infections or athlete’s foot—and it also isn’t the kind of serious yeast infection that physicians see sometimes in hospitals. In those cases, which are called candidemia, yeasts that are living benignly in someone’s intestines leak into the bloodstream and cause a whole-body infection that can be life-threatening. That is, people are the sources of their own infection.
In the case of this new yeast, the source of the infection isn’t the person who got sick. It seems instead to be the hospital environment, including catheters, counters, and other surfaces. Also, this new yeast is causing outbreaks, which again is very unusual and has epidemiologists alarmed.
Where is the new fungus coming from?
That isn’t clear. The organisms taken from infected people in other countries were related genetically in clades—think of them as being like families—that were similar within each country but unlike ones in other countries. The implication is that a single new superyeast has not arisen in one place and started moving across the world. Instead, perplexingly, separate strains seem to be rising in different places at the same time.
The cases in the United States that researchers have been able to analyze seem to be most like the yeasts circulating in South Asia and South America. But the U.S. patients didn’t travel to those areas, and only one had been outside the country recently, having been transferred from a hospital in the Middle East. That's leading the CDC to wonder whether, at some point in the past, some unidentified person crossed borders carrying C. auris unknowingly in their gut and introduced it here.
Why can’t this fungus be cured?
Yeasts are fungi, and antifungal drugs are in short supply, in part because they're not something that drug manufacturers see a big market for. Currently there are only three classes of antifungal drugs (compared to more than a dozen families of antibiotics), and C. auris is showing resistance to all three.
What is the biggest danger?
In every country where this yeast has appeared, the people who get sick have already been hospitalized. The U.S. patients, for instance, had cancers or grave chronic conditions. That means they're already receiving lots of drugs, which could undermine their immune systems, and they're touched by lots of caregivers and connected to lots of equipment, both of which could spread the organism onto their skin or into their bodies.
People with serious long-term conditions often cycle between different facilities, such as from a hospital to a long-term care unit or a nursing home, and it’s already known that such transfers can cause infections to spread back and forth through health care. So until the source of C. auris is found or a treatment is identified, isolating patients, enforcing strict precautions for health-care workers, and cleaning hospitals ultra-thoroughly may be the only protections.
“We consider this a serious threat that we want to act on aggressively,” Chiller says. “It is just not acting like a typical Candida. The fact that it is being transferred so readily in hospitals, the fact that it can develop really bad resistance, and the fact that it is hard to identify make it a real threat and a challenge.”







